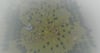

🎭 Karies Keep 🎭
On Sale
$15.00
$15.00
Includes:
- A variety of high quality models and buildings
- A medium-large sized map, with a raider fort, 2 villages, a walled fortress and many spread out outposts.
- Medieval music ambience.
- Includes an auto-uniform and helmet scripts.